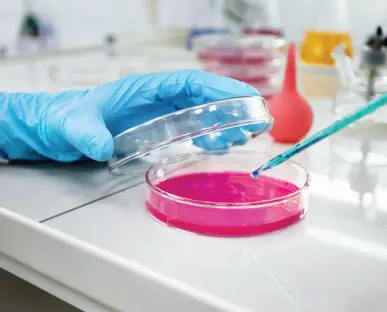

For Home Collection, Call Us: +91 78689 19991
Checkpoint - Your Partner in
Laboratory Services
Checkpoint was formed in 2012 with the vision to establish itself as a premier laboratory and a partner to clinicians to deliver personalized and high quality laboratory services. Today, we are the pre-eminent medical laboratory providing the most comprehensive menu of tests, the highest level of diagnostic automation with fully integrated systems and processes and quality of the highest standards.

Why Choose
Checkpoint
Diagnostics?

10+
Years of Experience
50K+
Happy Customers
5K+
Tests Per Annum
200+
Samples Processed/day
Top Common Tests
Blood Test
Test type: Blood
Analysing samples of blood to assess the general state of health.
Home Collection Available
Urine Test
Test type: Urine
Taking samples of urine or stool to identify diseases.
Home Collection Available

Affordable Health Packages
CP - 1000
- Blood Sugar Fasting
- Blood Sugar PP
- Complete Blood Count
- ESR
- Urea
- Creatinine
- Lipid Profile
- HbA1C
- Urine Complete
- ECG
₹1000/-
CP - 1500
- Blood Sugar Fasting
- Blood Sugar PP
- Complete Blood Count
- ESR
- Urea
- HbA1C
- Creatinine
- Urine Complete
- Liver Function Test (LFT)
- Lipid Profile
- Thyroid Profile
- ECG
₹1500/-
COVID-19 RT-PCR Sample collection at your doorstep
Get your COVID-19 RT-PCR Test done without leaving your home from Checkpoint Diagnostics. Our skilled phlebotomist will visit your home and collect the sample as per ICMR Guidelines.

Services we Offer

Book a Home Collection / Appointment Now!
Book a home visit now with Checkpoint Diagnostics and take a step towards a healthy life.
Words from Our Clients
“Checkpoint Lakshmi Nagar, Virudhunagar unit is doing smiley and prompt service at moderate cost. This lab is very useful to this area people' for normal check ups.”
Chelian Natarajan
Virudhunagar
"Very warm experience. Proactive staff. Very good experience"
Lakshmi
Virudhunagar
Quick and accurate reports... satisfying services..
selva mari priya
Virudhunagar
Find Your Nearest
Checkpoint Diagnostics
Find a checkpoint lab closest to you to
access the best diagnostic services
The Checkpoint
Loyalty Card
A loyalty program with just the customer
in mind is part of the health benefit plan


 Your Reports are Safe
Your Reports are Safe 
